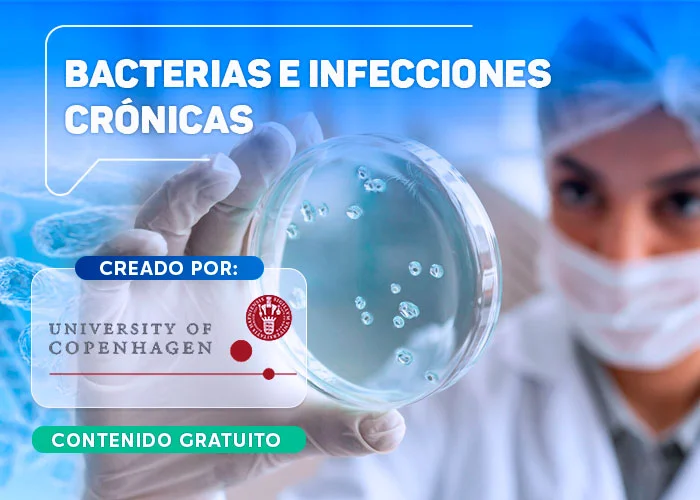
Bacterias infecciones cronicas

🔬 Impulsa tu carrera médica con cursos gratuitos de alto nivel
Accede a una selección exclusiva de cursos completos en medicina, diseñados por prestigiosas instituciones como la Pontificia Universidad Católica de Chile, la Universidad Nacional Autónoma de México (UNAM) y otras universidades de renombre internacional.
🌍 Aprende sin límites, a tu propio ritmo y según tu disponibilidad. La excelencia educativa está a tu alcance, sin costo alguno. 🎓 Nuestro compromiso es claro: facilitar el acceso a cursos gratuitos de calidad, tanto para médicos experimentados como para estudiantes apasionados de medicina, enfermería y tecnología médica.
🩺 El contenido completo de todos los cursos es libre y GRATUITO, únicamente si requieres el certificado oficial, emitido por cada Universidad, deberás pagar $49 USD.

Duración: 10 horas - Nivel: Principiante
En este curso, ofrecido por la UNAM, reconocerás una herramienta para evitar, manejar y controlar el sobrepeso y la obesidad, al destacar la importancia del autocuidado y el apoyo familiar en el manejo de este padecimiento. Te mostrará el verdadero valor de los alimentos como compañeros de tu vida, te alejará de los kilos de más y te forjará hábitos saludables que marcarán una senda de salud perdurable.
Duración: 10 horas - Nivel: intermedio
El manejo de heridas ha cambiado radicalmente en los últimos años, a través del desarrollo de evidencia científica. A lo largo de su vida profesional, todo personal de la salud se enfrentará al paciente con heridas, lo cual requiere conocimientos actualizados y efectivos. Actualmente, el profesional de enfermería se enfrenta a diario a diferentes situaciones relacionadas con las heridas agudas; sin duda, la infección es una de ellas e indudablemente de las de mayor impacto un abordaje interdisciplinar, haciendo especial hincapié en el exhaustivo lavado de manos, adecuado instrumental a utilizar así como la correcta realización de los distintos procedimientos con las medidas asépticas adecuadas y abordaje de la herida, sin olvidar la cura adecuada y el material idóneo. Esta dirigido para estudiantes de medicina, enfermería, paramédico y personal técnico del área de salud.
Duración: 8 horas - Nivel: intermedio
Este curso te permite adquirir competencias para reconocer los elementos de un modelo de atención a personas con enfermedades no transmisibles ENT, basándose en un marco conceptual y en estrategias aplicadas desde la atención primaria en salud, y desde el trabajo con las familias de personas que padecen este tipo de enfermedades.
Duración: 9 horas - Nivel: Principiante
En este curso aprenderás a diseñar actividades por simulación en el contexto de la salud para desarrollar y evaluar habilidades psicomotrices para el diagnóstico, tratamiento y prevención en el manejo integral del paciente. Aprenderás como tomar decisiones y plantear la solución de problemas clínicos.
Duración: 6 horas - Nivel: intermedio
El programa de diálisis peritoneal incluye conocimientos teórico-prácticos de índole resolutivo para la enseñanza del autocuidado en paciente que se dializan en su domicilio.
Se estructura a partir de las necesidades de formación que debe cubrir enfermería en las áreas de diálisis peritoneal. Se consideran como elementos básicos en este curso; conocimiento de la función normal del riñón, Enfermedad Renal Crónica (ERC) en sus diferentes estadios, valoración del paciente para ingreso a diálisis peritoneal, acceso peritoneal, cuidado del orificio de salida, medidas higiénicas, dietéticas, manejo de complicaciones en domicilio y los diferentes sistemas de conectología manual.
Duración: 13 horas - Nivel: Principiante
En este curso, el participante identificará entre una reacción adversa al medicamento, un evento temporalmente asociado a vacunas y las consecuencias adversas de las tecnologías médicas. Se busca la mejora de la seguridad del paciente al disminuir el riesgo de pérdida de la visión o afecciones oculares secundarias a través de la valoración del caso y la aplicación de técnicas diagnósticas oculares. La farmacovigilancia ocular es una actividad que puede realizar cualquier profesional de la salud, en el entendido de que busca la efectividad del fármaco y el seguimiento de problemas comunes poco identificados en la población, los cuales dependen de las potenciales interacciones medicamentosas (fármaco-fármaco, fármaco-alimento, fármaco-planta medicinal).
Duración: 7 horas - Nivel: Principiante
El profesional de la salud que lleve a cabo este curso tendrá presente la importancia de conocer el tema de cáncer de próstata, esto por ser el tumor maligno más frecuente en los hombres; además de identificar los factores de riesgo asociados a la presentación de la enfermedad y por tanto conocerá cómo se lleva a cabo el tamizaje en cáncer de próstata.
Podrá sugerir la manera en cómo se diagnostica, clasifica y etapifica esta enfermedad, así como el tratamiento por etapas clínicas.
Duración: 12 horas - Nivel: Principiante
Los médicos que estudian una especialidad médica se les conoce como “médicos residentes”, está ampliamente demostrado que tienen un importante rol docente con estudiantes de ciencias de la salud, residentes de años inferiores y sus pares. También se ha documentado que entrenar a los residentes y a sus maestros en este tema mejora la calidad y efectividad de la enseñanza en el contexto médico.
- Conceptos fundamentales del rol docente del médico residente
- La enseñanza de la clínica
- Cómo enseñar una destreza psicomotriz
- Cómo dar realimentación en la clínica
- Cómo dar una conferencia
- Aspectos básicos de liderazgo y manejo de conflictos.
Duración: 20 horas - Nivel: Intermedio
En el primer módulo, se presenta una perspectiva general sobre la definición y características, diagnóstico y tratamiento del dolor neuropático. El segundo módulo, se enfoca al dolor lumbar con radiculopatía, presentando sus características, recomendaciones para médicos y pacientes y aspectos clave de su diagnóstico y tratamiento. Los módulos tres y cuatro, se enfocan a la neuralgia postherpética y a la neuropatía diabética dolorosa, respectivamente. En todos los casos, la primera lección tiene un contenido general, no técnico, para consulta de todos los interesados; mientras que desde la segunda lección el contenido se especializa para profesionales de la salud.
Duración: 12 horas - Nivel: Intermedio
Este curso tiene como propósito promover una visión inclusiva en los equipos de salud sobre el protocolo de recuperación optimizada en pacientes operados de cirugía colorrectal, a través de información actualizada del manejo multidisciplinario abordando el flujo del paciente considerando el momento antes de la cirugía (prequirúrgico) el día de la cirugía (intraquirúrgico) y el momento posterior a ella (postquirúrgico), además, se abordarán los beneficios para los centros de salud evaluando el potencial impacto que un protocolo de recuperación optimizada podría tener.
Duración: 3 semanas - Nivel: Intermedio
Este curso te ofrece una oportunidad única de aprender de expertos destacados en la materia.
A lo largo del curso, te familiarizarás con:
- Conceptos básicos de microbiología y bacteriología: desde la estructura de las bacterias unicelulares hasta la formación de biopelículas.
- Diferencias entre infecciones agudas y crónicas: comprenderás cómo las bacterias pueden persistir en el cuerpo y causar enfermedades a largo plazo.
- Enfoque en las infecciones crónicas: profundizarás en ejemplos específicos como la osteomielitis, la enfermedad pulmonar obstructiva crónica (EPOC) y las infecciones por biopelículas.
- Estrategias para combatir las infecciones crónicas: conocerás los últimos avances en el tratamiento y la prevención de estas enfermedades.
Duración: 3 semanas - Nivel: Avanzado
Este curso de neurobiología avanzada explorar las maravillas del cerebro y cómo este nos permite percibir, pensar y actuar.
A lo largo del curso, descubrirás:
- Los secretos de la percepción: cómo el cerebro transforma las señales sensoriales en una representación del mundo que nos rodea.
- El poder del pensamiento: desde la formación de recuerdos hasta la toma de decisiones y la resolución de problemas.
- La conexión con el mundo exterior: cómo el cerebro controla el movimiento, las emociones y la interacción con el entorno.
- Los desafíos del envejecimiento y las enfermedades: cómo las conexiones neuronales se deterioran y cómo podemos proteger nuestro cerebro.
Duración: 3 semanas - Nivel: Intermedio
Explorarás la microbiología, la fisiopatología y la inmunología de cada caso, de una forma atractiva que te despertará la curiosidad por estas áreas.
Este curso forma parte de una iniciativa innovadora en educación médica, creada por un equipo de profesores de las mejores universidades de Estados Unidos.
La información proporcionada es solo para fines educativos, no para diagnóstico o tratamiento.
Duración: 3 semanas - Nivel: Principiantes
Este curso te ofrece una mirada completa e interdisciplinaria a la historia de la medicina, desde sus inicios en prácticas espirituales y místicas hasta el enfoque científico actual.
Explorarás:
- Terapias y prácticas a lo largo del tiempo.
- El alcance, la práctica y los límites de la medicina en diferentes épocas.
- La evolución del pensamiento médico desde el pasado lejano hasta el presente.
Duración: 3 semanas - Nivel: Principiantes
En este curso, descubrirás cómo los diferentes elementos del entorno, como el agua, el aire y las superficies, pueden facilitar la propagación de bacterias resistentes a los antibióticos y otras infecciones.
Aprenderás:
- Las principales vías de transmisión de las infecciones en el entorno.
- Las medidas de prevención más efectivas para evitar su propagación.
- Cómo aplicar las precauciones estándar y basadas en la transmisión en tu lugar de trabajo.
Duración: 3 semanas - Nivel: Principiantes
Este curso aprenderás sobre las diferentes etapas de la vida de la mujer, desde la infancia hasta la vejez, con un enfoque en la salud y los derechos humanos.
Aprenderás sobre:
- Los desafíos que enfrentan las mujeres en cada etapa de su vida.
- Las intervenciones positivas que pueden mejorar su salud y bienestar.
- La importancia de la igualdad de género para la salud global.
Participa en debates interactivos con tus compañeros y comparte tus experiencias y perspectivas.
Duración: 3 semanas - Nivel: Principiantes
No hace mucho tiempo, la muerte por enfermedades infecciosas era una realidad cotidiana. Si hubieras nacido hace 150 años, las probabilidades de morir por una de estas enfermedades antes de los 5 años eran extremadamente altas. Afortunadamente, la ciencia ha avanzado a pasos agigantados en la comprensión de las enfermedades infecciosas: su naturaleza, su propagación y su prevención.
Los desafíos persistentes
A pesar de los avances, enfermedades como el VIH/SIDA, la malaria, la tuberculosis y la gripe siguen siendo grandes asesinas en todo el mundo. Las nuevas enfermedades emergentes también son una amenaza constante para la salud pública. Además, las bacterias evolucionan y se vuelven resistentes a los antibióticos, nuestra arma más poderosa contra las infecciones bacterianas.
Duración: 3 semanas - Nivel: Avanzado
Los antibióticos son uno de los medicamentos más recetados, pero se estima que casi la mitad de su uso es inadecuado. Esto no solo afecta al paciente individual, sino que también contribuye a la resistencia a los antibióticos, un problema de salud pública grave.
Este curso te enseñará a usar los antibióticos de forma apropiada:
- Principios básicos del uso adecuado de antibióticos
- Aplicación de estos principios a infecciones comunes
- Desarrollo y mantenimiento de un programa de administración de antimicrobianos
Duración: 3 semanas - Nivel: intermedio
Este curso te ofrece una visión completa de los problemas que enfrenta la salud a nivel mundial. Para ello, se basa en el conocimiento de diversas áreas como la medicina, la salud pública, el derecho, la economía, las ciencias sociales y las humanidades.
A través de un enfoque interdisciplinario, el curso te guiará a través de siete temas críticos de la salud global. De esta manera, podrás comprender mejor las complejidades de este campo y las diferentes perspectivas que existen para abordarlo.
Duración: 3 semanas - Nivel: intermedio
El dolor crónico es un problema de gran magnitud, tanto en términos de salud pública como de costos económicos. Este curso te ofrece una combinación única de aprendizaje teórico y práctico para comprender mejor el dolor crónico y cómo prevenirlo mediante la autogestión en diferentes áreas de tu vida.
Objetivos del curso:
- Conocer la dimensión del problema: prevalencia, impacto personal y el desafío que representa para los sistemas de salud.
- Identificar las características clínicas y los factores que influyen en el dolor crónico: entenderás las diferentes causas del dolor, tanto físicas como psicológicas.
- Aprender estrategias para prevenir el dolor crónico: descubrirás herramientas prácticas para aplicar en tu vida diaria en siete áreas: cognitiva, conductual, física, emocional, espiritual, social y ambiental.
- Valorar el enfoque de sistemas humanos en la atención sanitaria: comprenderás cómo este enfoque integral puede mejorar la prevención del dolor y el bienestar general.
Duración: 3 semanas - Nivel: intermedio
Este curso te ofrece una oportunidad única para aprender sobre los últimos avances en el trasplante de riñón, páncreas e islotes. Dirigido a estudiantes de biomedicina, profesionales de la salud y cualquier persona interesada en esta área, el curso te brindará una formación completa a través de:
- Módulos: 4 módulos que abarcan todo el proceso del trasplante, desde la evaluación previa hasta los desafíos a largo plazo.
- Contenido: Conferencias, casos interactivos, películas en 3D, entrevistas con expertos y pacientes, y un juego serio para una experiencia de aprendizaje completa.
- Aval académico: Avalado por la Sociedad Europea de Trasplante de Órganos (ESOT), la Sociedad Internacional de Nefrología (ISN) y la Sociedad de Trasplantes (TTS).
- Créditos de formación médica continua (FMC): Acreditado para profesionales de la salud que completen el curso.
Duración: 3 semanas - Nivel: Principiante
Los signos vitales, como la frecuencia cardíaca, la presión arterial, la temperatura corporal, la frecuencia respiratoria y el dolor, son como ventanas que nos permiten observar el estado interno del cuerpo. En este curso de seis partes, te invitamos a explorar la anatomía y la fisiología que se esconden detrás de estas mediciones esenciales.
Aprenderás cómo funcionan los sistemas cardiovascular y respiratorio, y cómo su actividad influye en cada uno de los signos vitales. Descubrirás los rangos normales, las variaciones individuales y los mecanismos que provocan cambios en estas mediciones.
Además, el curso te ofrece demostraciones prácticas para que puedas aprender a medir correctamente los signos vitales tanto en ti mismo como en otras personas.
Duración: 3 semanas - Nivel: Principiante
La pandemia de COVID-19 puso de relieve la importancia de los modelos de transmisión de enfermedades infecciosas para la toma de decisiones en salud pública. Este curso te permitirá comprender cómo funcionan estos modelos, sus diferentes tipos y cómo usarlos de manera efectiva para la toma de decisiones.
¿Qué aprenderás?
- Fundamentos de los modelos de transmisión de enfermedades infecciosas
- Tipos de modelos: predicción, inferencia y teoría
- Evaluación de la utilidad, razonabilidad y pertinencia de un modelo
- Vulnerabilidades de los modelos
- Estudios de casos: ébola en África Occidental (2014-2016) y COVID-19
- Cómo los modelos informan las decisiones políticas
Duración: 3 semanas - Nivel: Avanzado
Explora la organización y la función del cerebro y la médula espinal, y cómo estas estructuras influyen en la sensación, la acción y la cognición.
En este curso, descubrirás:
- La organización de los sistemas neurales que median la sensación, la acción y la cognición.
- Cómo las señales sensoriales se integran con la memoria, la emoción y la cognición.
- Las bases neurobiológicas del comportamiento humano.
Este curso es ideal para:
- Estudiantes de medicina y otras ciencias de la salud.
- Cualquier persona interesada en comprender el funcionamiento del cerebro.
Duración: 3 semanas - Nivel: Principiante
Si la historia nos ha enseñado algo, es que la lucha entre la inteligencia y la voluntad humana contra la asombrosa capacidad de adaptación de los microbios nunca terminará. A pesar de los avances tecnológicos de las últimas décadas, la amenaza de las enfermedades infecciosas se ha intensificado considerablemente.
En este curso, exploraremos las razones detrás de esta realidad, examinando los principios científicos que rigen las epidemias y las estrategias de salud pública para su prevención y control en el siglo XXI.
Duración: 3 semanas - Nivel: Intermedio
Introducción:
- El curso presenta vídeos de disecciones humanas para comprender la estructura del cuerpo.
- Se advierte que las imágenes pueden ser perturbadoras.
Importancia de la anatomía:
- La anatomía humana es importante para artistas, médicos, científicos y muchas otras personas.
- Aprender la forma humana implicaba tradicionalmente la disección de cadáveres.
Recursos para el estudio de la anatomía:
- Este curso ofrece vídeos como un recurso adicional.
- Se requiere esfuerzo y diversos recursos para comprender la anatomía humana.
Objetivos del curso:
- Ayudar a comprender mejor la forma humana.
- Aumentar el valor del tiempo en el laboratorio (si es posible).
- Desarrollar una apreciación por la complejidad del cuerpo humano.
Duración: 3 semanas - Nivel: Avanzado
Este curso integral te brindará las bases sólidas para incursionar en la cirugía de cataratas, tanto por facoemulsificación como por extracción extracapsular. Abordaremos cada etapa, desde la evaluación preoperatoria hasta el cuidado postoperatorio, preparándote para tu experiencia en el quirófano.
Duración: 3 semanas - Nivel: Intermedio
La visualización biomédica es una disciplina en rápido crecimiento que está transformando la forma en que se visualiza, procesa y analiza la información en el ámbito académico, la investigación y la industria. Se considera el futuro de la ciencia, ya que ofrece nuevas técnicas y tecnologías para comprender mejor el cuerpo humano y sus procesos biológicos.
¿Qué aprenderás en este curso?
- Anatomía humana: Definirás y describirás la terminología anatómica relacionada con el cuerpo humano.
- Sistemas corporales: Comprenderás los diferentes sistemas corporales, sus componentes y su relación con la función.
- Modelado 3D: Crearás tus propios modelos y animaciones en 3D utilizando software estándar de la industria y de código abierto (Blender).
- Técnicas de visualización: Analizarás diversas técnicas y métodos de visualización y serás capaz de aplicarlos a diferentes áreas de la ciencia biomédica.
Duración: 3 semanas - Principiante
- Los sistemas de órganos: Sus funciones y cómo trabajan juntos para mantener la salud.
- Conceptos clave: Homeostasis, funcionamiento del cuerpo y principios fisiológicos.
- Sistemas en detalle: Nervioso, endocrino, cardiovascular, respiratorio, urinario, digestivo, reproductor y muscular.
- Aplicaciones prácticas: Cómo la fisiología se aplica a la vida real y a las enfermedades.
Ideal para:
- Estudiantes: Ampliar conocimientos y prepararse para exámenes como el MCAT.
- Profesionales de la salud: Refrescar sus conocimientos y adquirir nuevas perspectivas.
- Cualquier persona: Interesada en el cuerpo humano y su funcionamiento.
Duración: 3 semanas - Principiante
Más de 420 millones de personas en el mundo viven con diabetes, y dos tercios de ellas aún no lo saben. Esta enfermedad, cuando se detecta tarde o no se controla adecuadamente, puede tener graves consecuencias para la salud, como daños en el corazón, los vasos sanguíneos, los ojos, los riñones y los nervios, lo que puede conducir a la discapacidad y la muerte prematura. De hecho, la diabetes causa más muertes que el VIH/SIDA, la malaria y la tuberculosis juntas.
Este curso te ofrece una introducción a las últimas investigaciones en la prevención y el tratamiento de la diabetes, así como una comprensión más amplia de la situación en diferentes comunidades, tanto ricas como pobres, de todo el mundo, donde la diabetes amenaza la salud pública.
Duración: 3 semanas - Principiante
Abordaremos desde la biología básica de la enfermedad hasta las estrategias de prevención, pasando por los diferentes tipos de tratamiento y las claves para la supervivencia.
Explora junto a expertos de renombre:
- Conocerás los hitos científicos que han marcado la lucha contra este enemigo.
- Participarás en debates interactivos en foros y redes sociales.
- Podrás proponer temas para nuestros tweetchats y orientar el contenido a tus intereses.
Duración: 3 semanas - Principiante
Mejora significativamente la atención a tus pacientes con este curso innovador:
- Siete instructores de Yale de diversos campos te guiarán a través de un caso modelo interpretado por actores.
- Adquiere técnicas para:
- Evaluar el riesgo de trastorno por consumo de sustancias.
- Diagnosticar la gravedad del consumo.
- Gestionar planes de tratamiento.
- Derivar a los pacientes a los servicios adecuados.
- Navegar por las condiciones que limitan el acceso al tratamiento.
Al finalizar, estarás capacitado para brindar una atención compasiva y basada en la evidencia a una población vulnerable que enfrenta la adicción: una enfermedad crónica, con recaídas, pero tratable.
Duración: 3 semanas - Nivel: Intermedio
Las pruebas son el pilar de la medicina moderna. La investigación clínica nos brinda estas pruebas, guiando a los profesionales de la salud hacia soluciones a los problemas que enfrentan en la práctica diaria. Sin embargo, trasladar estos problemas a un entorno de investigación es un desafío que requiere una metodología precisa.
La epidemiología clínica es la herramienta que te permite abordar este desafío. Este curso te enseñará a:
- Aplicar los principios de la investigación a poblaciones humanas.
- Enfocarte en problemas clínicos específicos desde una perspectiva clínica.
- Traducir problemas reales en preguntas de investigación tangibles.
- Diseñar estudios epidemiológicos para obtener respuestas relevantes.
Duración: 3 semanas - Nivel: Principiante
Los combustibles fósiles, pilares de la sociedad desde la Revolución Industrial, impulsan la producción de una amplia gama de productos que utilizamos a diario. Sin embargo, en el siglo XXI, la necesidad de soluciones de fabricación más inteligentes, predecibles y sostenibles es apremiante.
La biotecnología industrial emerge como una alternativa atractiva a las tecnologías tradicionales. Esta disciplina transforma la forma en que producimos productos químicos y materiales, proporcionando además una fuente de energía renovable.
Este curso te sumergirá en el corazón de la fabricación sostenible, explorando:
- Tecnologías facilitadoras clave: Descubrimiento y diseño de enzimas, biología sintética y de sistemas, ingeniería bioquímica y de procesos.
- Innovación responsable: Bioética y consideraciones éticas en la investigación.
- Aplicaciones del mundo real: Casos de éxito en sectores como el farmacéutico, químico y de biocombustibles.
Duración: 3 semanas - Nivel: Principiante
Objetivo: Brindar información actualizada y práctica para mejorar la atención médica de pacientes con diabetes mellitus tipo 2.
Dirigido a: Médicos y profesionales de la salud que atienden a pacientes diabéticos.
Meta: Reducir la morbimortalidad y mejorar la calidad de vida de las personas con diabetes.
Contenido:
- Manejo nutricional: Estrategias personalizadas para una alimentación saludable.
- Actividad física: Planes de ejercicio seguros y efectivos.
- Manejo farmacológico: Opciones de tratamiento según el contexto clínico, comorbilidades y preferencias del paciente.
- Toma de decisiones compartida: Enfoque centrado en el paciente para un mejor control de la diabetes.
Beneficios:
- Mejora en la atención médica: Implementación de estrategias actualizadas para el manejo integral de la diabetes.
- Reducción de complicaciones: Disminución del riesgo de enfermedades cardiovasculares, renales, entre otras.
- Mejora en la calidad de vida: Mayor bienestar y control de la diabetes para los pacientes.
Duración: 3 semanas - Nivel: intermedio
El mundo biomédico y sanitario está viviendo una avalancha de datos. Desde información genómica hasta historiales electrónicos de pacientes y datos de dispositivos wearables, la cantidad de información disponible es cada vez mayor.
La ciencia de datos emerge como la herramienta clave para transformar este panorama. Gracias a los avances en este campo, las ciencias de la vida están evolucionando hacia una medicina de precisión y una asistencia sanitaria estratificada.
Este curso te sumerge en el corazón de esta revolución. Aprenderás sobre los distintos tipos de datos y métodos computacionales que se utilizan para ofrecer una atención médica personalizada y precisa.
No solo adquirirás conocimientos teóricos: trabajarás con datos reales, poniendo en práctica lo aprendido. Además, expertos líderes en el campo te compartirán casos de éxito y te mostrarán cómo la ciencia de datos está transformando la salud.
Duración: 3 semanas - Nivel: intermedio
La EHGNA es una epidemia global que afecta a una de cada cuatro personas. Esta enfermedad no solo daña el hígado, sino que también aumenta el riesgo de enfermedades cardíacas y cáncer de hígado.
Este curso te ofrece una comprensión profunda de la EHGNA. Comenzaremos por explorar la fisiología del hígado humano, sentando las bases para comprender la enfermedad. Luego, nos adentraremos en la epidemiología, fisiopatología, medicina clínica y genética de la EHGNA.
Aprenderás sobre:
- Diagnóstico preciso: Análisis de sangre, diagnóstico por imagen e histología.
- Complicaciones y manejo: Desde la cirrosis hasta el cáncer de hígado, y las opciones de tratamiento disponibles.
- Relación con la diabetes: Una conexión importante que no debe pasarse por alto.
- Nuevos biomarcadores: Tecnologías ómicas para la detección temprana y el desarrollo de nuevos tratamientos.
Duración: 3 semanas - Nivel: Principiantes
Aprenderás de:
- Científicos de alto nivel de la Universidad de Copenhague, una de las instituciones líderes en investigación sobre diabetes.
- Expertos en biología, genética, clínica, prevención y epidemiología de la diabetes y la obesidad.
Contenido:
- Aspectos biológicos: Desde la fisiología hasta la genética y la epigenética.
- Enfoque clínico: Diagnóstico, tratamiento y complicaciones de la diabetes y la obesidad.
- Prevención y epidemiología: Estrategias para reducir la incidencia y el impacto de estas enfermedades.
Beneficios:
- Actualización de conocimientos: Accede a la investigación más reciente en diabetes y obesidad.
- Enfoque multidisciplinario: Obtén una comprensión integral de estas enfermedades.
- Impacto en la práctica: Aplica lo aprendido para mejorar la atención a tus pacientes.